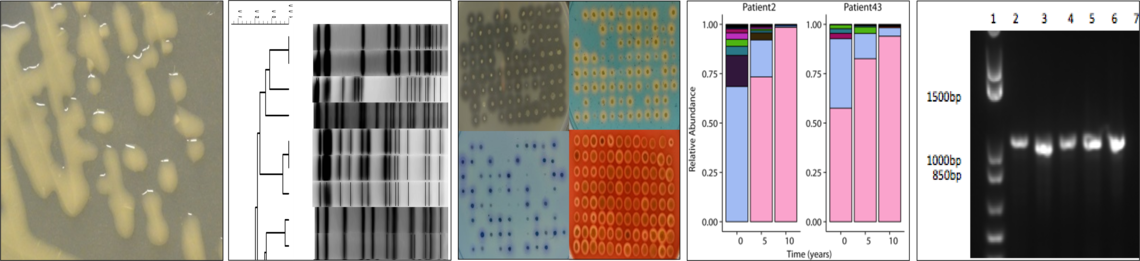
image

The themes of our research program are as follows:
1. Understanding the natural history of CF-related lung infections.
2. Identifying infectious markers to predict the clinical course of CF lung disease and the successful resolution of pulmonary exacerbations.
3. Understanding how the microbiome is affected by existing CF-therapies and how these correlate with clinical response.
4. Wastewater-based detection of human pathogens at a different range of locations.